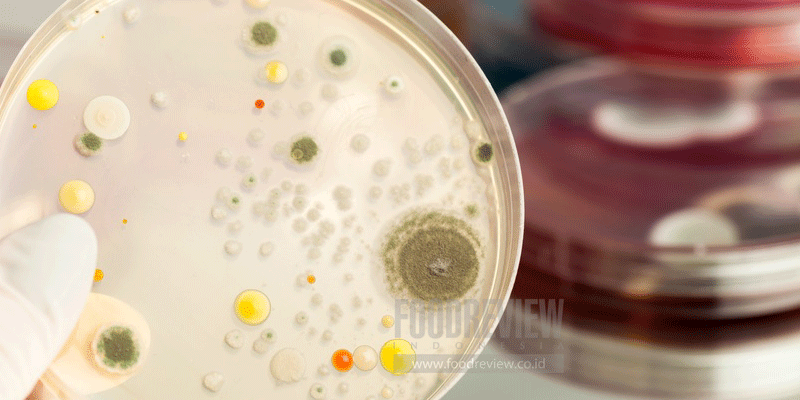

Proses terbentuknya biofilm pada permukaan padat telah dijelaskan dalam berbagai literatur. Pada awalnya bakteri dapat menempel secara acak dan dapat balik (reversibel) yang antara lain dapat dipengaruhi oleh adanya senyawa yang teradsorpsi pada permukaan, tumbukan secara acak, motilitas bakteri, porositas permukaan, reologi aliran dan lain-lain. Penempelan dapat balik ini dapat berkembang menjadi penempelan tak dapat balik (irreversible) apabila terjadi ikatan kimiawi yang makin kuat antara bakteri dan permukaan, seperti ikatan hidrogen, hidrofobik, ikatan kovalen dan sebagainya.
Hal ini menyebabkan pertumbuhan bakteri dan produksi polisakarida ekstraseluler yang memerangkap bakteri lainnya ke dalam komunitas biofilm. Biofilm yang terbentuk dapat mengalami pelepasan berupa sloughing atau erosion yang dapat terjadi karena beberapa sebab, antara lain meningkatnya kandungan gula dalam fase cair. Resultan antara jumlah bakteri yang menempel dan yang melepaskan diri itulah yang tercermin sebagai densitas atau populasi biofilm. Donlan (2002) merangkum berbagai faktor yang penting yang berpengaruh terhadap penempelan sel bakteri dan pembentukan biofilm. Faktor-faktor tersebut dapat berasal dari sel mikroorganisme, permukaan padat maupun aliran cairan yang bersinggungan dengan permukaan padat tersebut.
Lebih lengkapnya silahkan baca di FOODREVIEW INDONESIA edisi "Food Safety By Design", November 2017

